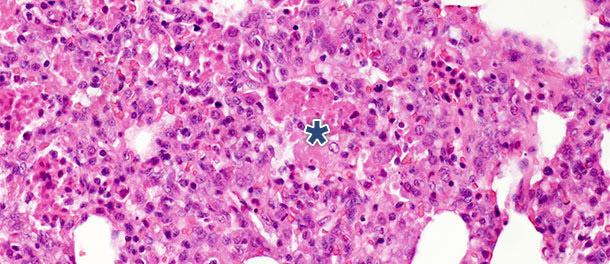

La pathogénèse et les lésions dues à l’infection du virus du SDRP dépendent beaucoup des caractéristiques communes aux virus appartenant au genre Arterivirus : (i) capacité d’entrer et de se répliquer dans leurs cellules cible, les macrophages ; (ii) virémie prolongée après l’infection ; (iii) infection persistante de longue durée (non permanente). La phase aigüe de la virémie chez les porcs d’engraissement dure environ 4 semaines, après cette période le virus se trouvera essentiellement dans le tissu lymphoïde, normalement pendant le reste de sa vie pour un animal de production, et la virémie peut se reproduire périodiquement (revu en détail dans Chand et al. 2012, Curr Opin Virol).
Les lésions induites par les virus respiratoires dans le tissu pulmonaire peuvent se développer par deux voies principales : la dérégulation par destruction directe des pneumocytes et/ou l’infection des cellules inflammatoires et immunitaires qui induisent le dommage tissulaire par la libération de cytokines actives ou de métabolites nocifs. Ces cellules actives peuvent « recruter » d’autres cellules inflammatoires vers le point d’infection en augmentant le dommage tissulaire, bien qu’elles aient aussi un rôle important dans l’élimination virale et la régulation de l’inflammation.

Les cellules cibles dans les infections dues par le virus du SDRP sont les macrophages alvéolaires. Le dommage tissulaire est la conséquence de l’apoptose directe (et de la nécrose) de ces cellules et en grande partie, de leurs cellules voisines (effet bystander) dû à la libération de cytokines apoptogénes, réactions de l’oxygène et de l’oxyde nitrique. En même temps, des cytokines pro-inflammatoires sont libèrées qui sont responsables du recrutement d’autres cellules inflammatoires , certaines d’entre elles entraînant des symptômes systémiques (fièvre, léthargie, etc …). Elles sécrètent aussi des cytokines anti-inflammatoires et régulatrices. Il est bien connu que, comme d’autres virus, le virus du SDRP a la capacité de supprimer la réponse primaire de l’interféron de type I – un mécanisme puissant antiviral de l’immunité innée, dans les premières phases de l’infection par ses protéines non structurelles, ce qui lui permet de se répliquer et de se disséminer de façon plus efficace. Cependant, différents isolats du virus du SDRP ont différentes capacités immunomodulatrices, par conséquent, les lésions et le résultat global de l’infection dépendent beaucoup du poids des mécanismes que nous venons de décrire. Le dommage/destruction des macrophages peut faciliter l’apparition des infections secondaires comme on l’observe souvent en conditions de terrain.
Lors d’infections expérimentales réalisées dans des élevages isolés, les signes cliniques et les lésions observées dépendent beaucoup de la pathogénicité de la souche utilisée pour inoculer les animaux. Les lésions respiratoires les plus sévères sont observées à 7-14 jours PI. Macroscopiquement, il s’agit de zones consolidées, foncées et tachetées qui affectent plus gravement les lobules cranio-ventraux, mais qui peuvent se trouver disséminées dans tout le tissu pulmonaire (photo 1). Les principales lésions histopathologiques comprennent : (1) hypertrophie et hyperplasie pneumocytaires, (2) infiltration mononucléaire septale, (3) débris nécrotiques intra-alvéolaires, (4) accumulation intra-alvéolaire de cellules inflammatoires et (5) accumulation péri-vasculaire de cellules inflammatoires.

Photo 1 : poumons d’un porcelet sacrifié 14 jours PI, inoculé avec une souche à forte pathogénicité de type 1 sous-type 3 « Lena ».".
Dans une étude avec challenge dans laquelle on a euthanasié les porcs à 14 et 21 jours PI, on a observé chez les animaux infectés une diminution significative des débris nécrotiques intra-alvéolaires et des cellules inflammatoires à 21 jours PI. En revanche, on a observé un léger changement dans les trois autres catégories. Ces découvertes peuvent être expliquées par le fait que la formation des débris nécrotiques intra-alvéolaires et par conséquent l’accumulation intra-alvéolaire des cellules inflammatoires (essentiellement granulocytes neutrophiles) reflètent la phase aigüe de la maladie (photo 2) dans lesquelles les substances nocives libérées par les macrophages infectés entraînent une importante atteinte tissulaire. Après la phase initiale et aigue, en l’absence d’infection bactérienne secondaire, le système immunitaire et les mécanismes naturels de guérison éliminent le tissu nécrotique, c’est pourquoi les cellules de l’inflammation aigue (granulocytes neutrophiles) disparaissent, les alvéoles se vident et les pneumocytes endommagés sont remplacés par des pneumocytes prolifératifs de type II.
Photo 2 : débris nécrotiques intra-alvéolaires et accumulation de cellules inflammatoires (astérisque) dans le tissu pulmonaire à 10 jours après PI avec un isolat du virus du SDRP de type 1 sous-type 1 H. E. 200 x.
Les pneumocytes de type II sont des cellules de forme cubique qui sont souvent localisées à l’insertion des septums alvéolaires. Dans le tissu pulmonaire des mammifères, ils constituent 60% de toutes les cellules alvéolaires épithéliales, mais ils couvrent seulement environ 5% de la superficie alvéolaire. Leur rôle le plus important est la synthèse, la sécrétion et le recyclage du surfactant pulmonaire qui diminue la tension superficielle alvéolaire, prévenant le collapsus pendant l’expiration. L’autre fonction importante des pneumocytes de type II se trouve dans leur potentialité proliférative. Quand les pneumocytes de type I sont endommagés, ceux du type II agissent comme des cellules souches pour les remplacer et, avec le temps, se différencient en pneumocytes de type I. Dans le challenge décrit ci-dessus, le nombre de ces cellules a augmenté significativement sur les 10 jours PI (photo 3) et n’a pas diminué à 21 jours PI. Bien que l’étude se soit terminée à 10 jours PI et que l’on n’a pas observé de guérison histologique totale (restitutio ad integrum) dans le groupe infecté, les animaux ont récupéré de la maladie clinique et le nombre élevé de pneumocytes de type II après l’inoculation autant sur les phases initiales que sur les phases finales de la maladie ont démontré leur importance dans la guérison du tissu pulmonaire (description en détails dans Balka et al.2013. J Comp Pathol).

Photo 3 : les points marron indiquent le noyau des pneumocytes de type II identifiés avec des anticorps anti-TTF-1. On a observé une augmentation significative du nombre de cellules positives à 10 jours après l’infection avec un isolat de type I sous-type 1. IHC 200x.








